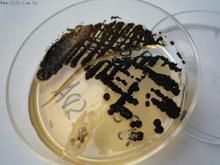
土生隱球菌 土生隱球菌

基本信息
產品ID號:47124
產品編號:CL1101
中文名稱:土生隱球菌ATCC9949
英文名稱:
產品規格:5支/包裝
產品類別:質控菌株>>Remel質控菌株
Culti-Loops質控菌株接種環為5支/包裝,除彎曲菌屬需冷凍保存(-18℃)外,其它都應在2-8℃保存。
土生隱球菌 ATCC 9949
D-蟲螢光素游離酸/(S)-4,5-二氫-2-(6-羥基苯並噻唑-2-基)噻唑-4-甲酸/D-螢光素/D-冷光素/D-Luciferin
D-地衣酸/(+)-松蘿酸/松蘿酸/地衣酸/D-2,6-二乙醯基-7,9-二羥基-8,9b-二甲基-1,3(2H,9bH)-二苯並呋喃二酮/(+)-Usniacin
D-泛醇/右旋泛醇/(R-)2,4-二羥基-N-(3-羥基丙基)-3,3-二甲基丁醯胺/D-(+)-2,4-二羥基-N-(3-羥丙基)-3,3-二甲基丁醯胺/右泛醇/右旋泛醯醇/D-泛醯醇/維生素原B5/D-Panthenol